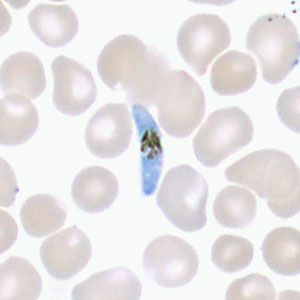
May - 2017 - Case #443 Case 443

2017 DPDx Case Studies

Several people developed gastrointestinal symptoms of watery diarrhea, nausea with vomiting, and low-grade fever approximately 1 week after attending a catered event. Stool specimens were collected for laboratory testing which included a formalin-ethyl acetate concentration with brightfield wet mount examination.
DPDx is an educational resource designed for health professionals and laboratory scientists. For an overview including prevention, control, and treatment visit www.cdc.gov/parasites/.